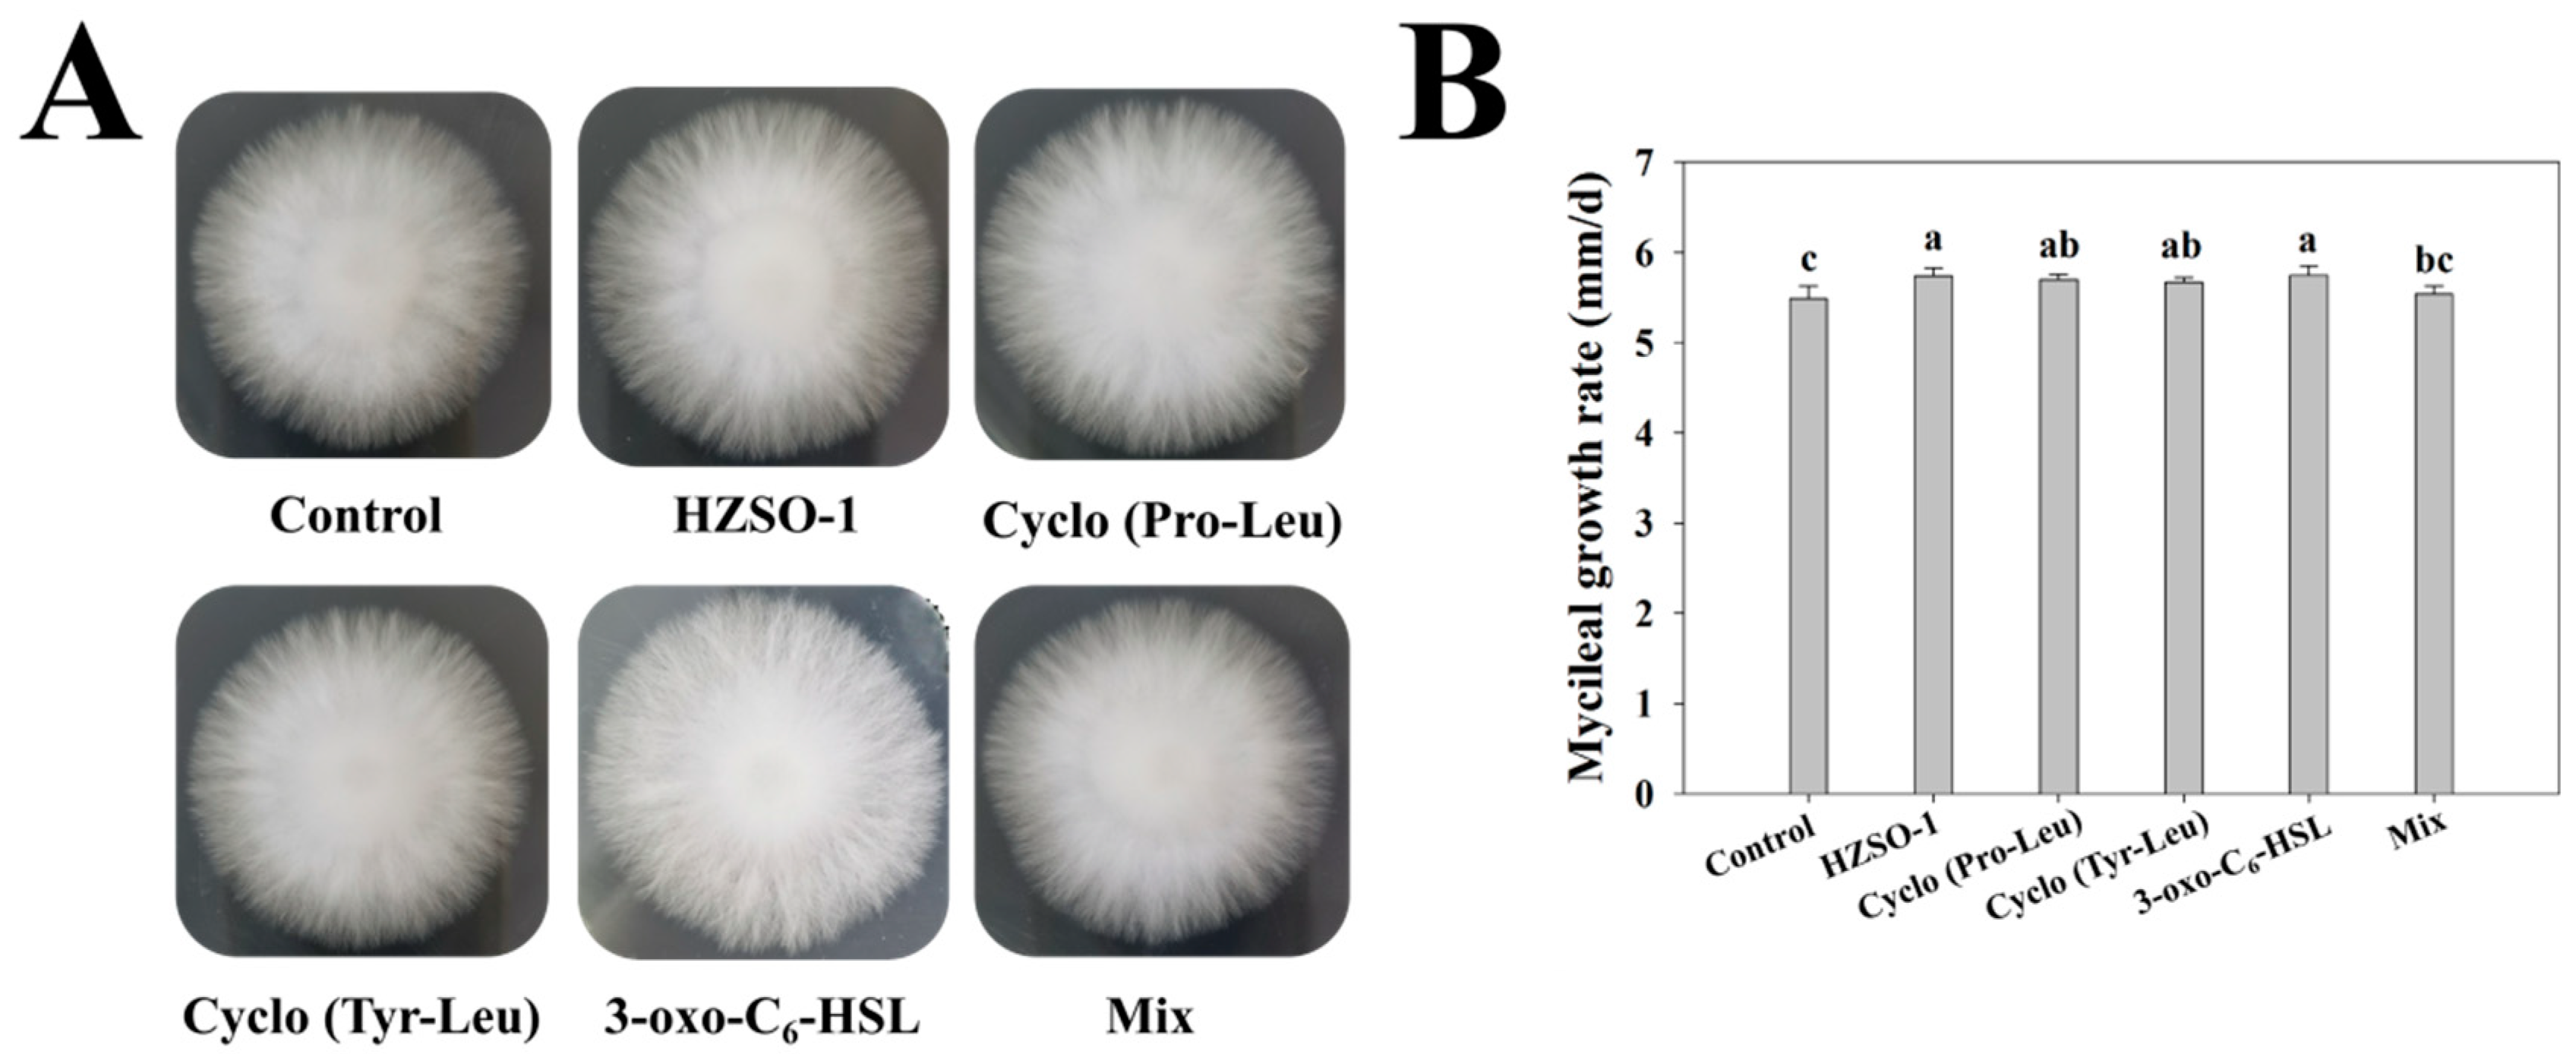
Biomolecules 13 01804 g001

The Promoting Mechanism of the Sterile Fermentation Filtrate of Serratia odorifera on Hypsizygus marmoreus by Means of Metabolomics Analysis
Abstract
:1. Introduction
2. Materials and Methods
2.1. Strain Culture and Chemical Synthesis
2.2. Screening of the Optimal Concentration of the Sterile Broth of S. odorifera
2.3. Screening for Optimal Concentration of Signal Molecule Markers
2.4. Mycelium Ultrastructure Observation
2.5. Metabolite Extraction and Machine Detection Conditions
2.6. UHPLC-QE-MS Analysis
2.6.1. Preprocessing of Original Data and Metabolite Description
2.6.2. Metabolite Classification Statistics
2.6.3. Multivariate Statistical Analysis
2.6.4. Screening and Analyzing Differential Accumulated Metabolites (DAMs)
2.6.5. Metabolic Pathway Analysis of DAMs
2.7. Statistical Analysis
3. Results
3.1. Effect of Sterile Fermentation Broth of S. odorifera and Different QS-Signaling Molecules on Mycelial Growth of H. marmoreus
3.2. Effect of Sterile Fermentation Filtrate of S. odorifera and Different QS Signal Molecules on the Microstructure of H. marmoreus Mycelium
3.3. Effect of Sterile Fermentation Filtrate of S. odorifera and Different QS Signal Molecules on the Metabolome of H. marmoreus Mycelium
3.4. Screening and Analysis of the DAMs
3.5. Analysis of the Pathways of the Different Metabolites
4. Discussion
5. Conclusions
Supplementary Materials
Author Contributions
Funding
Institutional Review Board Statement
Informed Consent Statement
Data Availability Statement
Conflicts of Interest
References
- Wang, G.; Lin, J.; Shi, Y.; Chang, X.; Wang, Y.; Guo, L.; Wang, W.; Dou, M.; Deng, Y.; Ming, R.; et al. Mitochondrial genome in Hypsizygus marmoreus and its evolution in Dikarya. BMC Genom. 2019, 20, 765. [Google Scholar] [CrossRef] [PubMed]
- Kumari, S.; Naraian, R. Enhanced growth and yield of oyster mushroom by growth-promoting bacteria Glutamicibacter arilaitensis MRC119. J. Basic. Microbiol. 2021, 61, 45–54. [Google Scholar] [CrossRef] [PubMed]
- Noble, R.; Dobrovin-Pennington, A.; Hobbs, P.J.; Pederby, J.; Rodger, A. Volatile C8 compounds and pseudomonads influence primordium formation of Agaricus bisporus. Mycologia 2009, 101, 583–591. [Google Scholar] [CrossRef] [PubMed]
- Kertesz, M.A.; Thai, M. Compost bacteria and fungi that influence growth and development of Agaricus bisporus and other commercial mushrooms. Appl. Microbiol. Biotechnol. 2018, 102, 1639–1650. [Google Scholar] [CrossRef] [PubMed]
- Cho, Y.S.; Kim, J.S.; Crowley, D.E.; Cho, B.G. Growth promotion of the edible fungus Pleurotus ostreatus by fluorescent pseudomonads. FEMS Microbiol. Lett. 2003, 218, 271–276. [Google Scholar] [CrossRef] [PubMed]
- Sun, S.; Li, F.; Xu, X.; Liu, Y.; Kong, X.; Chen, J.; Liu, T.; Chen, L. Study on the community structure and function of symbiotic bacteria from different growth and developmental stages of Hypsizygus marmoreus. BMC Microbiol. 2020, 20, 311. [Google Scholar] [CrossRef] [PubMed]
- Kai, M.; Effmert, U.; Berg, G.; Piechulla, B. Volatiles of bacterial antagonists inhibit mycelial growth of the plant pathogen Rhizoctonia solani. Arch. Microbiol. 2007, 187, 351–360. [Google Scholar] [CrossRef] [PubMed]
- Tan, B.; Jackson, T.A.; Hurst, M.R. Virulence of Serratia strains against Costelytra zealandica. Appl. Environ. Microbiol. 2006, 72, 6417–6418. [Google Scholar] [CrossRef]
- Weissmann, R.; Uggla, C.; Gerhardson, B. Field performance of a weed-suppressing Serratia plymuthica strain applied with conventional spraying equipment. BioControl 2003, 48, 725–742. [Google Scholar] [CrossRef]
- Fuqua, C.; Parsek, M.R.; Greenberg, E.P. Regulation of gene expression by cell-to-cell communication: Acyl-homoserine lactone quorum sensing. Annu. Rev. Genet. 2001, 35, 439–468. [Google Scholar] [CrossRef]
- Wong, C.S.; Yin, W.F.; Choo, Y.M.; Sam, C.K.; Koh, C.L.; Chan, K.G. Coexistence of quorum-quenching and quorum-sensing in tropical marine Pseudomonas aeruginosa strain MW3A. World J. Microbiol. Biotechnol. 2012, 28, 453–461. [Google Scholar] [CrossRef] [PubMed]
- Marketon, M.M.; Glenn, S.A.; Eberhard, A.; González, J.E. Quorum sensing controls exopolysaccharide production in Sinorhizobium meliloti. J. Bacteriol. 2003, 185, 325–331. [Google Scholar] [CrossRef] [PubMed]
- Yang, Q.; Defoirdt, T. Quorum sensing positively regulates flagellar motility in pathogenic Vibrio harveyi. Environ. Microbiol. 2015, 17, 960–968. [Google Scholar] [CrossRef] [PubMed]
- Liu, L.; Zeng, X.; Zheng, J.; Zou, Y.; Qiu, S.; Dai, Y. AHL-mediated quorum sensing to regulate bacterial substance and energy metabolism: A review. Microbiol. Res. 2022, 262, 127102. [Google Scholar] [CrossRef] [PubMed]
- Von Rad, U.; Klein, I.; Dobrev, P.I.; Kottova, J.; Zazimalova, E.; Fekete, A.; Hartmann, A.; Schmitt-Kopplin, P.; Durner, J. Response of Arabidopsis thaliana to N-hexanoyl-DL-homoserine-lactone, a bacterial quorum sensing molecule produced in the rhizosphere. Planta 2008, 229, 73–85. [Google Scholar] [CrossRef] [PubMed]
- Ortíz-Castro, R.; Martínez-Trujillo, M.; López-Bucio, J. N-acyl-L-homoserine lactones: A class of bacterial quorum-sensing signals alter post-embryonic root development in Arabidopsis thaliana. Plant Cell Environ. 2008, 31, 1497–1509. [Google Scholar] [CrossRef]
- Rice, S.A.; Koh, K.S.; Queck, S.Y.; Labbate, M.; Lam, K.W.; Kjelleberg, S. Biofilm formation and sloughing in Serratia marcescens are controlled by quorum sensing and nutrient cues. J. Bacteriol. 2005, 187, 3477–3485. [Google Scholar] [CrossRef]
- Schuhegger, R.; Ihring, A.; Gantner, S.; Bahnweg, G.; Knappe, C.; Vogg, G.; Hutzler, P.; Schmid, M.; Van Breusegem, F.; Eberl, L.; et al. Induction of systemic resistance in tomato by N-acyl-L-homoserine lactone-producing rhizosphere bacteria. Plant Cell Environ. 2006, 29, 909–918. [Google Scholar] [CrossRef]
- Liu, X.; Bimerew, M.; Ma, Y.; Müller, H.; Ovadis, M.; Eberl, L.; Berg, G.; Chernin, L. Quorum-sensing signaling is required for production of the antibiotic pyrrolnitrin in a rhizospheric biocontrol strain of Serratia plymuthica. FEMS Microbiol. Lett. 2007, 270, 299–305. [Google Scholar] [CrossRef]
- Sun, S.; Liu, Y.; Weng, C.; Sun, S.; Li, F.; Li, H.; Zhu, H. Cyclic dipeptides mediating quorum sensing and their biological effects in Hypsizygus marmoreus. Biomolecules 2020, 10, 298. [Google Scholar] [CrossRef]
- Cao, J.; Sun, M.; Yu, M.; Xu, Y.; Xie, J.; Zhang, H.; Chen, J.; Xu, T.; Qian, X.; Sun, S. Transcriptome analysis reveals the function of a G-protein α subunit gene in the growth and development of Pleurotus eryngii. J. Fungi 2023, 9, 69. [Google Scholar] [CrossRef] [PubMed]
- Wen, X.; Geng, F.; Xu, Y.; Li, X.; Liu, D.; Liu, Z.; Luo, Z.; Wang, J. Quantitative transcriptomic and metabolomic analyses reveal the changes in Tricholoma matsutake fruiting bodies during cold storage. Food Chem. 2022, 381, 132292. [Google Scholar] [CrossRef] [PubMed]
- Potocnik, I.; Rekanovic, E.; Todorovic, B.; Lukovic, J.; Paunovic, D.; Stanojevic, O. The effects of casing soil treatment with Bacillus subtilis Ch-13 biofungicide on green mould control and mushroom yield. Pestic. Phytomed. 2019, 34, 53–60. [Google Scholar] [CrossRef]
- Zarenejad, F.; Yakhchali, B.; Rasooli, I. Evaluation of indigenous potent mushroom growth promoting bacteria (MGPB) on Agaricus bisporus production. World J. Microbiol. Biotechnol. 2012, 28, 99–104. [Google Scholar] [CrossRef] [PubMed]
- Wang, H.; Shi, Y.; Wang, D.; Yao, Z.; Wang, Y.; Liu, J.; Zhang, S.; Wang, A. A biocontrol strain of Bacillus subtilis WXCDD105 used to control tomato Botrytis cinerea and Cladosporium fulvum cooke and promote the growth of seedlings. Int. J. Mol. Sci. 2018, 19, 1371. [Google Scholar] [CrossRef] [PubMed]
- Kai, M.; Piechulla, B. Impact of volatiles of the rhizobacteria Serratia odorifera on the moss Physcomitrella patens. Plant Signal. Behav. 2010, 5, 444–446. [Google Scholar] [CrossRef] [PubMed]
- Kim, M.K.; Math, R.K.; Cho, K.M.; Shin, K.J.; Kim, J.O.; Ryu, J.S.; Lee, Y.H.; Yun, H.D. Effect of Pseudomonas sp. P7014 on the growth of edible mushroom Pleurotus eryngii in bottle culture for commercial production. Bioresour. Technol. 2008, 99, 3306–3308. [Google Scholar] [CrossRef]
- Rinschen, M.M.; Ivanisevic, J.; Giera, M.; Siuzdak, G. Identification of bioactive metabolites using activity metabolomics. Nat. Rev. Mol. Cell. Biol. 2019, 20, 353–367. [Google Scholar] [CrossRef]
- Mülleder, M.; Calvani, E.; Alam, M.T.; Wang, R.K.; Eckerstorfer, F.; Zelezniak, A.; Ralser, M. Functional metabolomics describes the yeast biosynthetic regulome. Cell 2016, 167, 553–565.e12. [Google Scholar] [CrossRef]
- Macheleidt, J.; Mattern, D.J.; Fischer, J.; Netzker, T.; Weber, J.; Schroeckh, V.; Valiante, V.; Brakhage, A.A. Regulation and role of fungal secondary metabolites. Annu. Rev. Genet. 2016, 50, 371–392. [Google Scholar] [CrossRef]
- McCotter, S.W.; Horianopoulos, L.C.; Kronstad, J.W. Regulation of the fungal secretome. Curr. Genet. 2016, 62, 533–545. [Google Scholar] [CrossRef] [PubMed]
- Stuart, K.A.; Welsh, K.; Walker, M.C.; Edrada-Ebel, R. Metabolomic tools used in marine natural product drug discovery. Expert. Opin. Drug. Discov. 2020, 15, 499–522. [Google Scholar] [CrossRef] [PubMed]
- Yan, Z.; Zhao, M.; Huang, C.; Zhang, L.; Zhang, J. Trehalose alleviates high-temperature stress in Pleurotus ostreatus by affecting central carbon metabolism. Microb. Cell Fact. 2021, 20, 82. [Google Scholar] [CrossRef] [PubMed]
- Cook, C.; Francocci, F.; Cervone, F.; Bellincampi, D.; Bolwell, P.G.; Ferrari, S. Combination of pretreatment with white rot fungi and modification of primary and secondary cell walls improves saccharification. Bioenerg. Res. 2015, 8, 175–186. [Google Scholar] [CrossRef]
- Li, Z.Y.; Azi, F.; Ge, Z.W.; Liu, Y.F.; Yin, X.T.; Dong, M.S. Bio-conversion of kitchen waste into bacterial cellulose using a new multiple carbon utilizing Komagataeibacter rhaeticus: Fermentation profiles and genome-wide analysis. Int. J. Biol. Macromol. 2021, 191, 211–221. [Google Scholar] [CrossRef] [PubMed]
- Lin, H.; Li, N.; Li, J.; Sun, S.; Zhang, L.; Hu, K. Correlation analysis between Hypsizygus marmoreus fruiting yield and metabolism of intracellular and extracellular carbon. Mycosystema 2022, 41, 1506–1518. [Google Scholar] [CrossRef]
- Lin, H.; Li, P.; Ma, L.; Lai, S.; Sun, S.; Hu, K.; Zhang, L. Analysis and modification of central carbon metabolism in Hypsizygus marmoreus for improving mycelial growth performance and fruiting body yield. Front. Microbiol. 2023, 14, 1233512. [Google Scholar] [CrossRef]
- El-Awady, R.; Saleh, E.; Hashim, A.; Soliman, N.; Dallah, A.; Elrasheed, A.; Elakraa, G. The role of eukaryotic and prokaryotic ABC transporter family in failure of chemotherapy. Front. Pharmacol. 2017, 7, 535. [Google Scholar] [CrossRef]
- Baral, B. Evolutionary trajectories of entomopathogenic fungi ABC transporters. Adv. Genet. 2017, 98, 117–154. [Google Scholar] [CrossRef]
- Hogan, D.A. Talking to themselves: Autoregulation and quorum sensing in fungi. Eukaryot. Cell 2006, 5, 613–619. [Google Scholar] [CrossRef]

Disclaimer/Publisher’s Note: The statements, opinions and data contained in all publications are solely those of the individual author(s) and contributor(s) and not of MDPI and/or the editor(s). MDPI and/or the editor(s) disclaim responsibility for any injury to people or property resulting from any ideas, methods, instructions or products referred to in the content. |
© 2023 by the authors. Licensee MDPI, Basel, Switzerland. This article is an open access article distributed under the terms and conditions of the Creative Commons Attribution (CC BY) license (https://creativecommons.org/licenses/by/4.0/).
Share and Cite
Cao, J.; Xie, J.; Yu, M.; Xu, T.; Zhang, H.; Chen, L.; Sun, S. The Promoting Mechanism of the Sterile Fermentation Filtrate of Serratia odorifera on Hypsizygus marmoreus by Means of Metabolomics Analysis. Biomolecules 2023, 13, 1804. https://doi.org/10.3390/biom13121804
Cao J, Xie J, Yu M, Xu T, Zhang H, Chen L, Sun S. The Promoting Mechanism of the Sterile Fermentation Filtrate of Serratia odorifera on Hypsizygus marmoreus by Means of Metabolomics Analysis. Biomolecules. 2023; 13(12):1804. https://doi.org/10.3390/biom13121804
Chicago/Turabian StyleCao, Jixuan, Jiacheng Xie, Mingming Yu, Tao Xu, Huangru Zhang, Liding Chen, and Shujing Sun. 2023. "The Promoting Mechanism of the Sterile Fermentation Filtrate of Serratia odorifera on Hypsizygus marmoreus by Means of Metabolomics Analysis" Biomolecules 13, no. 12: 1804. https://doi.org/10.3390/biom13121804
APA StyleCao, J., Xie, J., Yu, M., Xu, T., Zhang, H., Chen, L., & Sun, S. (2023). The Promoting Mechanism of the Sterile Fermentation Filtrate of Serratia odorifera on Hypsizygus marmoreus by Means of Metabolomics Analysis. Biomolecules, 13(12), 1804. https://doi.org/10.3390/biom13121804





